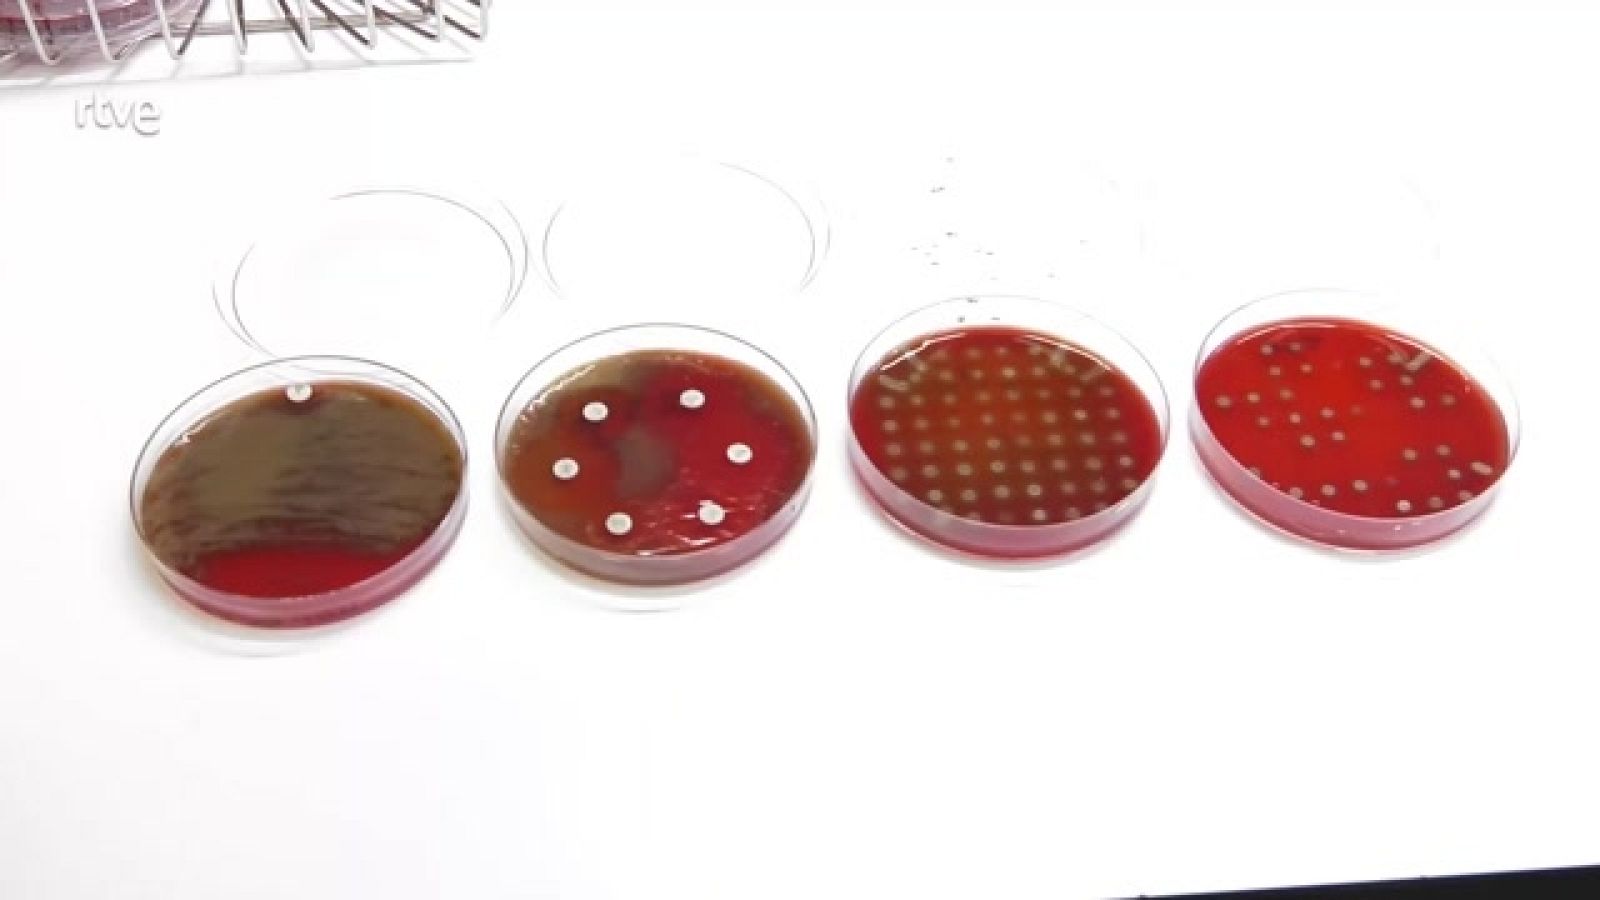
Aquí hay trabajo - Nueva Ley de la Ciencia contra la precariedad laboral - ver ahora

Aquí hay trabajo
Nueva Ley de la Ciencia contra la precariedad laboral
Nueva Ley de la Ciencia contra la precariedad laboral
28/09/2022 00:05:05